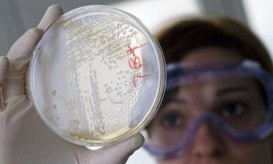

Έμπολα στη ΛΔ Κονγκό: Τι γνωρίζουμε μέχρι στιγμής για την επιδημία
Αν επιβεβαιωθούν όλα τα ύποπτα κρούσματα, αυτή η επιδημία του ιού έμπολα θα καταταχθεί ως η 7η μεγαλύτερη που...

Αν επιβεβαιωθούν όλα τα ύποπτα κρούσματα, αυτή η επιδημία του ιού έμπολα θα καταταχθεί ως η 7η μεγαλύτερη που...

Όπως έγινε γνωστό χτες ο Παγκόσμιος Οργανισμός Υγείας (ΠΟΥ) ανακοίνωσε πως ο νέος κορωνοϊός που ξεκίνησε από την Κίνα...

Χωρίς όπλα στη φαρέτρα τους, εξέχοντες επιστήμονες στον τομέα της έρευνας, δηλώνουν απαισιόδοξοι για την εξέλιξη της επιδημίας που...

Ο αστάθμητος παράγοντας μπορεί να φέρει το χάος σε μια επιδημία, πολύ περισσότερο όταν αυτή έχει την τάση να...

Σε ύψιστη ετοιμότητα για επικείμενη διασπορά της ασθένειας COVID-19 που προκαλεί ο κορωνοϊός βρίσκονται οι υγειονομικές αρχές στη χώρα...

Υπάρχει μια κατηγορία συμπολιτών μας που εμφανίζονται περισσότερο ευάλωτοι στη νέα επιδημία και για το λόγο αυτό θα πρέπει...

Η επιδημία του κοροναϊού που ξεκίνησε στην Κίνα στις αρχές Δεκεμβρίου, έγινε παγκόσμιο πρόβλημα μέσα σε μόλις 2 μήνες,...

Ανήσυχοι είναι οι Έλληνες επιστήμονες του Εθνικού Οργανισμού Δημόσιας Υγείας (ΕΟΔΥ), οι οποίοι παρακολουθούν και ενημερώνονται κάθε στιγμή, για...

Η ανθρωπότητα επέδειξε επικίνδυνο εφησυχασμό στην αντιμετώπιση της παγκόσμιας επιδημίας του AIDS και αυτό έχει ως συνέπεια να καθυστερεί...

Σοκ προκαλεί η εκτίμηση ότι η επιδημία χολέρας στην Υεμένη, που έχει προκαλέσει ήδη περισσότερους από 1.800 θανάτους, μπορεί...
Στρατιώτες εκπαιδευμένοι στον βιολογικό πόλεμο έφτασε στη βόρεια Σιβηρία για την αντιμετώπιση επιδημίας άνθρακα που έχει στοιχίσει μέχρι στιγμής...

"Σήμερα, στον δυτικό κόσμο, είναι ανήκουστο να πεθαίνουν παιδιά από ασθένειες όπως η πολιομυελίτιδα, και η ευλογιά αποτελεί πλέον...

Σε διπλό μέτωπο δίδεται η μάχη κατά του φονικού Έμπολα στην Αφρική: την ώρα που ερευνητές προσπαθούν να αναχαιτίσουν...

Οι Γιατροί Χωρίς Σύνορα έδωσαν στη δημοσιότητα μία ανάλυση της επιδημίας του ιού Έμπολα στη Δυτική Αφρική κατά το...

Η διάλυση που επέφερε στις υπηρεσίες υγείας χωρών της Δυτικής Αφρικής η επιδημία του Έμπολα ανοίγει τον δρόμο σε...